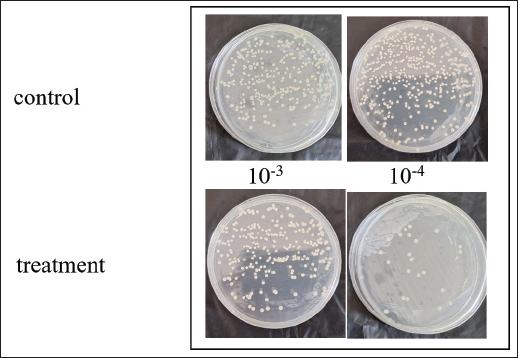

| Research Article | ||
Open Vet. J.. 2025; 15(5): 2182-2192 Open Veterinary Journal, (2025), Vol. 15(5): 2182-2192 Research Article Mechanism of recombinant 1,3-β-glucanase as antibiofilm to prevent antimicrobial resistance in antifungal therapy for vulvovaginitis candidiasisMasfufatun Masfufatun1*, Afaf Baktir2 and Rini Purbowati31Department of Biochemistry, Faculty of Medicine, Universitas Wijaya Kusuma Surabaya, Surabaya, Indonesia 2Department of Chemistry, Faculty of Science and Technology, Universitas Airlangga, Surabaya, Indonesia 3Department of Biomedical and Biomolecular Research, Faculty of Medicine, Universitas Wijaya Kusuma Surabaya, Surabaya, Indonesia *Corresponding Author: Masfufatun Masfufatun. Department of Biochemistry, Faculty of Medicine, Universitas Wijaya Kusuma Surabaya, Surabaya, Indonesia. Email: masfufatun [at] uwks.ac.id Submitted: 22/02/2025 Revised: 04/04/2025 Accepted: 09/04/2025 Published: 31/05/2025 © 2025 Open Veterinary Journal
ABSTRACTBackground: Candida albicans is an opportunistic pathogen that can form biofilms, thereby increasing resistance to antifungals such as fluconazole. The extracellular matrix of biofilms rich in β-1,3-glucans is the main barrier to the penetration of antifungal drugs. Aim: This study aimed to study the mechanism of recombinant β-1,3-glucanase activity as an antibiofilm agent to increase the effectiveness of antifungals in treating vulvovaginitis candidiasis (VVC). Methods: Recombinant β-1,3-glucanase was produced using recombinant DNA technology and tested for its antibiofilm activity against C. albicans biofilms. Tests were carried out at the adhesion stage, biofilm formation, and mature biofilm using the crystal violet assay, scanning electron microscope (SEM), confocal laser scanning microscope (CLSM) methods, and cell viability tests. The combination of β-1,3-glucanase with fluconazole was also evaluated to measure its synergistic effect on biofilm matrix degradation and cell viability. Results: The results showed that recombinant β-1,3-glucanase affected all stages of C. albicans biofilm formation. Recombinant β-1,3-glucanase was able to inhibit biofilm matrix formation by 86.05% and reduce C. albicans cell viability by 75.43% when combined with fluconazole. SEM and CLSM analyses revealed significant damage to the 3D structure of the biofilm, demonstrating the synergistic effectiveness of the combination of the two agents. The combination of recombinant β-1,3-glucanase with fluconazole in vitro was shown to be effective in inhibiting biofilm formation and eradicating mature C. albicans biofilms. Conclusion: These findings indicate the great potential of β-1,3-glucanase to be applied as an antifungal concomitant agent for overcoming antimicrobial resistance in biofilm infections such as VVC. Further studies are needed to evaluate the effectiveness of the drug in in vivo models and clinical applications. Keywords: Antimicrobial resistance, C. albicans biofilm, Fluconazole, Recombinant β-1,3-glucanase, Vulvovaginitis candidiasis. IntroductionVulvovaginitis Candidiasis (VVC) is a global health problem that occurs in women worldwide. According to data from the World Health Organization, women will experience a Candida albicans fungal infection at least once in 75% of their lifetime (Achkar and Fries, 2010), 5%–8% will experience chronic Candida infections, and 40%–50% will experience recurrent infections (Pirotta and Garland, 2006). In Indonesia, VVC is also a common health problem. According to data from the Indonesian Ministry of Health in 2020, fungal infections of the reproductive system accounted for 22.3% of all cases of infection in women. VVC itself accounts for approximately 50% of cases of fungal infections of the reproductive system. Among the numerous cases of vaginitis, VVC is the second most common type of bacterial vaginosis. In the United States, the estimated cost of health care related to vaginitis is approximately $1.8 billion per year (De Bernardis et al., 2018). This phenomenon is related to the existence of mono-biofilms or polymicrobial Candida biofilms that cause antifungal resistance. Biofilms are a community of microorganisms embedded in an extracellular matrix, with the main component being β-1,3 glucan for Candida biofilms, which form a complex three-dimensional architecture. The presence of this extracellular matrix is what Candida uses as protection against the host’s immune system and increased antimicrobial resistance (Sardi et al., 2013). Kidney or liver damage is a serious side effect of antifungal therapeutic drug use, and the use of high-concentration drugs has been shown to be inefficient in inhibiting growth and/or eliminating biofilms (Lohse et al., 2018). The first-line therapy for fungal infections and broad-spectrum antifungal drugs is Amphotericin B (AMB) (Benincasa et al., 2011; Vikelouda et al., 2017; Yan et al., 2019). However, C. albicans biofilms exhibit high resistance to AMB, being 1,000 times more resistant than their planktonic form. AMB is an example of a drug delivery system that enhances therapeutic effects and reduces toxicity (Weiler et al., 2008; Nieto et al., 2018). However, its high production cost has widely hindered the use of this formulation (Weiler et al., 2009; Steimbach et al., 2017). Therefore, it is necessary to have an accompanying agent that can degrade biofilms to prevent resistance and increase the efficiency of antifungal performance. One of the accompanying agents of biofilm degradation is the enzyme glucanase. Snails (Achatina fulica), which are often found in plantations, can produce glucanase enzymes. Masfufatun et al. (2014) isolated the enzyme from the liquid digestive gland of A. fulica. This enzyme extract hydrolyzes the glucan substrate (laminarin) into glucose (Masfufatun et al., 2014). When combined with small molecules, the A. fulica enzyme consortium was reported to eliminate Candida biofilms and increase fluconazole performance by 68% in vitro (Baktir et al., 2012) and 53.58% in the intestinal mucosa of candidiasis rats (Masfufatun et al., 2022). In 2018, Kurniawati et al. (2018) successfully cloned the gene encoding β-1,3-glucanase (MKAFGluI) from A. fulica digestive gland extract via library construction metagenomics. The MKAFGlu1 gene encodes a protein in the form of the enzyme 1,3-β-glucanase, which was successfully expressed in the Escherichia coli host (Kurniawati et al., 2018, 2019, 2020) and Pichia pastoris (Afaf Baktir, in review). The success of this cloning technology opens up opportunities for the development of research in the health sector to use recombinant β-1,3 glucanase as a companion agent in preventing antifungal resistance caused by Candida polymicrobial biofilms. The purpose of this study was to investigate the mechanism of recombinant β-1,3-glucanase activity as an antibiofilm agent to increase the effectiveness of antifungals in treating VVC. Materials and MethodsStrains, media, and reagentsCandida albicans, a biofilm-forming fungus, was isolated from patients who had VVC, a condition diagnosed using polymerase chain reaction and culture techniques (Masfufatun et al., 2024). The microorganism culture was grown in Sabouraud dextrose broth (SDB) medium (Himedia, India) at 37°C for 18–20 hours. RPMI 1640 medium (Sigma–Aldrich (Austria) was used for biofilm growth. BMGY and BMYY media to produce β-1,3-glucanase enzyme MKAFGlu1. Production of β-1,3-glucanase MKAFGlu1 from recombinant P. pastoris KM71H [pPICZαA – MKAFGlu1]The stock solution of glycerol of recombinant P. pastoris KM71H yeast [pPICZαA-MKAFGlu1] was taken using a loop and streaked onto the surface of YPDS agar media containing Zeosin aseptically and then incubated at 28°C–30°C for 4 days. The cultivated single colony of P. pastoris was resuspended in 2.5 ml of phosphate-buffered saline (PBS) solution, and the suspension was transferred into BMGY medium. The culture was incubated at a temperature of 28°C–30°C and shaken at a speed of 200–250 rpm for 16–18 hours. After incubation, the cells were centrifuged for 5 minutes at a temperature of 4°C. The resulting pellet was resuspended in BMMY for recombinant protein expression. The suspension was incubated at a temperature of 28°C–30°C and shaken at a speed of 200–250 rpm, and methanol was added every 24 hours. The enzyme was harvested at 72 hours by centrifuging the suspension at a maximum speed for 3 minutes at a temperature of 4°C to obtain the supernatant, which was the recombinant enzyme extract (Baktir, in Review). Cultivation of C. albicansSingle colonies from C. albicans that grew on solid Sabauroud Dextrose Agar (SDA) were inoculated into 10 ml of SDB liquid medium and aerated on a rotary shaker at 150 rpm at 37°C for 18–20 hours. After 15 minutes at room temperature, the inoculum was centrifuged at 3,000 rpm. After discarding the centrifuge’s supernatant, PBS was used to wash the cell pellet. The centrifugation and washing steps were repeated three times. The pellet from the third centrifugation was resuspended in RPMI 1640 media until the OD600 was 0.56. The C. albicans suspension was prepared for use in the next stage of the study. Mechanism of β-1,3-glucanase as an antibiofilmEffect of β-1,3-glucanase enzyme on adhesion ability of C. albicans The adherence of C. albicans was tested with and without the addition of β-1,3-glucanase. A 96-well microplate was filled with 100 µl of the C. albicans suspension in each well. Then, 100 µl of 0.216 mg/µl of β-1,3-glucanase was added to each well of the microplate treatment group and 100 µl of RPMI medium in the control group. The microplate was incubated for 90 minutes at 37°C for the adhesion phase and evaluated using a spot assay. Adhesion test on the well walls of the microtiter plate The adhesion test was performed using a spot test. After 90-minute of incubation, to remove nonadherent cells, PBS was used to rinse the 96-well plate. Cells attached to the walls of the microplate wells were suspended in PBS. The suspension was serially diluted and grown on SDA medium (Himidia, India) and incubated for 24 hours at 37oC. Colony density was observed as spots and counted using the colony-forming units (CFUs) method. Effect of β-1,3-glucanase on C. albicans biofilm matrix formation Two experiments were conducted to test biofilm matrix formation with and without β-1,3-glucanase. A 100 µl of C. albicans inoculum suspension (107 cells/ml) was placed into the wells of a 96-well microplate and incubated for 90 minutes at 37°C for the adhesion phase. After cell attachment, the planktonic cells were discarded. The suspension was replaced with a β-1,3-glucanase enzyme solution with different concentrations (0.027 and 0.216 mg/µl) in RPMI 1640 media until the total volume of each well is 100 μl. As a control, RPMI 1640 medium was used without β-1,3-glucanase. 96-well microplates were reincubated for 48 hours at 37°C, and matrix tests and Biofilm observations were performed. Effect of β-1,3-glucanase on mature biofilms The C. albicans cell inoculum suspension (100 µl) was applied to each microplate well. The microplate wells were rinsed with PBS to remove nonadherent cells after an adhesion phase of 90 minutes at 37°C. Then, a new RPMI 1640 medium was added. The microplates were incubated at 37°C for 48 hours for the formation of mature biofilms in the microplate wells. The microplate wells were washed twice with PBS, and β-1,3-glucanase was added at concentrations (0.027 and 0.216 mg/µl) in RPMI 1640 media to a total volume of 100 μl per well. RPMI media without β-1,3-glucanase was used as a control. The 96-well Microplate was then incubated again for 24 hours at 37°C, and a biofilm matrix test was performed. β-1,3-glucanase activity as a concomitant antifungal agentAs an antifungal during the stage of biofilm matrix production and mature biofilm, fluconazole (Flu, 0.1 mg/ml) was employed in conjunction with β-1,3-glucanase in this experiment. The wells of a 96-well microplate were filled with 100 µl of a C. albicans inoculum suspension (107 cells/ml, and the microplate was incubated for 90 minutes at 37°C. Fluconazole (Flu 0.1 mg/ml), β-1,3-glucanase (E), or an antifungal and β-1,3-glucanase combination (E + Flu) were added to the suspension after cell attachment. The suspension was replaced with RPMI 1640 media as a negative control. Following a 48-hour reincubation period at 37°C, cell viability tests and biofilm observations were performed. The activity of β-1,3-glucanase as an accompanying agent in mature biofilms was assessed by adding 100 µl of cell suspension to each microplate well and incubating them for 90 minutes at 37°C. The wells were filled with fresh RPMI 1640 media and incubated for 48 hours at 37°C after non-adherent cells were removed using PBS. Additionally, the developed mature biofilms were treated with 100 µl β-1,3-glucanase (E), 100 µl of fluconazole (Flu 0.1 mg/ml), or an 100 µl fluconazol and β-1,3-glucanase combination (E + Flu). RPMI 1640 media (100 µl) was used as a negative control. Following a 24-hour reincubation period at 37°C, cell viability tests and biofilm observations were performed. Candida albicans biofilm matrix assayThe biofilm matrix test for C. albicans was conducted with crystal violet (CV). Following biofilm formation, the planktonic cells in the 96-well microplate were removed, and the biofilm was cleaned twice with PBS and preserved for 15 minutes with methanol. After washing the wells another PBS wash, 150 µl of a 0.1% (w/v) CV solution was added, and the wells were left for 30 minutes. After binding to the biofilm, CV was shaken at room temperature and extracted using 200 µl of 96% ethanol. The biofilm matrix’s OD600 was determined using a microplate reader. Cell viability testingViability test was performed based on the protocol kit (CellTiter 96® AQueous One Solution Reagent from Promega). After the biofilm in the microplate was washed with PBS, 20 µl of (3-(4,5-dimethylthiazol-2-yl)-5-(3-carboxymethoxyphenyl)-2-(4-sulfophenyl)-2H-tetrazolium) (MTS) reagent solution was added to each well of the microplate containing the C. albicans biofilm. The reagent was allowed to spread evenly without shaking. The microplate was then incubated at 37°C for 1 hour. Active metabolite cells reduce the MTS reagent to formazan and produce a color change. Optical density (OD) was measured at a wavelength of 490 nm using a microplate reader. Cell viability was calculated by comparing the OD of the sample with that of the control. Evaluation of biofilms using a confocal laser scanning microscope (CLSM)Biofilms were grown on coverslips inserted into 24-well microplates. The biofilm formation procedure was the same as the previous step. After the 24-well microplates containing antifungal drugs (Flu), β-1,3-glucanase (E), or a combination of antifungal or β-1,3-glucanase (E + Flu) were incubated for 24 hours at 37°C, the wells were washed twice with sterile PBS. Furthermore, fixation was carried out 3× with methanol pa for 30 minutes each. The coverslips were removed from the microplates, washed 2× with sterile distilled water, stained with Ruby Stain-SYPRO (Invitrogen, USA), and incubated for 60 minutes in the dark. Furthermore, the coverslips were washed with PBS and re-stained with Syto 9 dye (2.5 µM) (Invitrogen, USA) for 20 minutes in the dark, and then observed under a CLSM. Evaluation of biofilm with scanning electron microscope (SEM)Biofilms were grown on coverslips placed into 24-well microplates for the purpose of evaluating the antibiofilm activity of β-1,3-glucanase alone or a combination of antifungal and β-1,3-glucanase using a SEM. The biofilm formation procedure was the same as before: 24-well microplates containing antifungal drugs (Flu), β-1,3-glucanase (E), or with a combination of antifungal or β-1,3-glucanase (E + Flu) were incubated for 48 hours at 37oC, and the wells were washed twice with sterile PBS. Additionally, fixation was performed three times with methanol pa for 30 minutes each. Following chemical dehydration with Hexamethyldisilazane (Sigma-Aldrich, St. Louis, MO), the samples were coated with gold and examined using a SEM. Data analysisStatistical Product and Service Solutions is a statistical program used to analyze research data. For statistical comparisons, we used one-way ANOVA. The threshold for statistical significance (p < 0.05). Unless specified otherwise, data are shown as means and standard errors of the mean for three independent replications, including three technical replications each. The test groups that exhibited significant differences were determined using post hoc testing. Ethical approvalThe research has received ethical approval from the Research Ethics Commission Universitas Wijaya Kusuma (No.94/SLE/FK/UWKS/2024). ResultsMechanism of action of β-1,3-glucanase as an anti-biofilmThe mechanism of action of recombinant β-1,3-glucanase as an antibiofilm was investigated by analyzing the impact of recombinant β-1,3-glucanase administration on the adhesion, colonization, and maturation stages of C. albicans biofilm formation. The initial attachment of Candida cells was inhibited after 90 minutes of recombinant β-1,3-glucanase administration at the adhesion stage, in contrast to the control group (recombinant β-1,3-glucanase). The number of C. albicans colonies in the treatment group was lower (2.2. 107 CFU/ml) than that of the control (2.97. 108 CFU/ml) (Fig. 1). The findings of the biofilm matrix test utilizing the CV Test technique showed that recombinant β-1,3-glucanase at different doses was able to significantly destroy mature biofilms and limit the production of C. albicans biofilms (Fig. 2). β-1,3-glucanase was able to prevent the formation of biofilm matrices by 92.09% and destroy established biofilms by 78.1% at a dosage of 0.216 mg/µl. Biofilms of C. albicans were also observed using SEM. A complex and dense network of yeast, hyphae, pseudohyphae, and biofilm matrix was generated by the biofilms in the control group (Fig. 3A). On the other hand, following β-1,3-glucanase treatment, virtually no biofilm structure was observed (Fig. 3B). β-1,3-glucanase activity as a concomitant antifungal agentβ-1,3-glucanaseand antifungal combination for biofilm inhibition Based on the results of the viability test using MTS (Fig. 4), Fluconazole (0.1 mg/ml) alone reduced cell viability by 21.45%. When the biofilm was treated with Fluconazole and β-1,3-glucanase together, the viable cells (cell viability) decreased by 72.99%.
Fig. 1. The first interaction between β-1,3-glucanase and the cell surface. After 90 minutes of incubation with β-1,3-glucanase, the adherence of Candida cells was evaluated using a spot assay.
Fig. 2. Recombinant β-1,3-glucanase’s antibiofilm activity in the development of biofilm matrix and mature biofilm in a 96-well microplate. Recombinant β-1,3-glucanase was given concurrently with biofilm formation for 48 hours and after biofilm maturity at several doses (0.027 and 0.216 mg/ml). The resultant biofilm biomass was compared with that of the control biofilm, which was devoid of β-1,3-glucanase. The results are presented as a percentage of the biofilm matrix. The mean ± SD is used to express the results. Significant differences (p < 0.05) are shown by different superscript letters.
Fig. 3. SEM images of biofilms on the surface of 96-well microplates without (A) or with (B) β-1,3-glucanase, (1) yeast, (2) pseudohypha, and (3) extracellular matrix. CLSM (biofilm matrix staining and cell viability) images confirmed the results of the CV (Fig. 2) and MTS (Fig. 4) tests. The CLSM results in Figure 5 show that the biofilm treated with a combination of Fluconazole and β-1,3-glucanase had lower red and green color intensities than those of fluconazole treatment. Treatment with Flu (0.1 mg/ml) decreases the intensity of the biofilm matrix (green color) by 37.6% and the viability of C. albicans cells (red) by 8.05%. When the biofilm was treated with a combination of Fluconazole and β-1,3-glucanase, it decreased the intensity of the biofilm matrix by 75.5% and the viability of C. albicans cells by 59.8%. The biofilm treated with Fluconazole and β-1,3-glucanase also had a lower 3D structure, which suggests that fluconazole killed many of the biofilm’s cells and β-1,3-glucanase broke down the biofilm architectures. β-1,3-glucanase and antifungal combination for mature biofilmsBased on the results of the cell viability test using MTS (Fig. 7), Fluconazole (0.1 mg/ml) alone reduced cell viability in the biofilm by 18.8%. When the biofilm was treated with a combination of Fluconazole andβ-1,3-glucanase together, the viable cells (cell viability) decreased by 79.2%.
Fig. 4. Impact of β-1,3-glucanase and antifungal combination on 96-well microplate biofilm development. The combination of β-1,3-glucanase and an antifungal was administered together when biofilm formation for 48 hours. A comparison was made between a biofilm treated with antifungal agents alone and a control biofilm (without β-1,3-glucanase). The collected values were expressed as percentages of cell viability. The findings are shown as mean ± SD. Significant differences (p < 0.05) are indicated by different superscript letters.
Fig. 5. CLSM images of biofilms on the surface of coverslips treated without β-1,3-glucanase or Flu (Control), with Fluconazole (F) alone, and with a combination of β-1,3-glucanase and Flu (E+F) together with biofilm formation. The biofilm matrix was stained with Ruby, which absorbed red, and the cell viability was stained with Syto 9, which absorbed green. CLSM images (biofilm matrix staining and cell viability) confirmed the results of the CV (Fig. 3) and MTS (Fig. 6) tests. The CLSM results in Figure 7 showed that the biofilm treated with the combination of Fluconazole and β-1,3-glucanase had lower red and green color intensities compared with the biofilm treated with Fluconazole. Treatment with Flu (0.1 mg/ml) decreased the intensity of the biofilm matrix (green color) by 28.84% and the viability of C. albicans cells (red) by 17.04%. In combination, Fluconazole and β-1,3-glucanase can reduce the biofilm matrix intensity by 86.05% and the viability of C. albicans cells by 75.43%. Furthermore, the combination of Fluconazole and β-1,3-glucanase reduced the biofilm’s 3D structure, suggesting that fluconazole killed more cells in the biofilm and β-1,3-glucanase broke down the biofilm’s architecture.
Fig. 6. The impact of β-1,3-glucanase and antifungal on a 96-well microplate’s mature biofilm. After the mature biofilm formed in 48 hours, it was treated for 24 hours with a combination of β-1,3-glucanase and antifungal. A comparison was made between a biofilm treated with antifungal agents alone and a control biofilm (without β-1,3-glucanase). The results are presented as a percentage of cell viability. The results are shown as mean ± SD. Significant differences are indicated by different superscript letters (p < 0.05).
Fig. 7. CLSM images of mature biofilms on the surface of coverslips treated without β-1,3-glucanase or Fluconazole (Control), with Fluconazole (F) alone, with a combination of β-1,3-glucanase and Fluconazole (E+F). The biofilm matrix was stained with Ruby, which absorbed red, and the cell viability was stained with Syto 9, which absorbed green. DiscussionBiofilm formation by C. albicans has an important clinical impact, namely increased resistance of cells in the biofilm to antifungal therapy (Wall et al., 2019). This resistance is due to the contribution of the extracellular matrix in protecting biofilm cells from environmental disturbances, thereby reducing drug penetration and encouraging genetic resistance mechanisms (Pierce et al., 2017; Chamtouri et al., 2024; Waykar and Kumarapillai, 2024). One component of the extracellular matrix, β-1,3-glucan, is known to contribute to azole resistance by specific binding (Tsui et al., 2016). The β-1,3-glucan content in C. albicans cells increases twofold when in biofilm form (Nett and Andes, 2006). Therefore, the existence ofβ-1,3-glucan is a strategic target for breaking down the biofilm matrix protection. β-1,3-glucanase is a protein that can degrade the β-1,3-glycosidic bonds in β-1,3-glucan so that it can weaken the biofilm matrix structure and increase the effect of antimicrobial drugs (Tan et al., 2018). This enzyme can be obtained from the digestive tract of A. fulica. In previous research, Baktir et al. (2012) used an enzyme consortium from A. fulica to eradicate C. albicans biofilm. This enzyme consortium successfully inhibited the formation of C. albicans biofilm by 22.5% and was able to increase the performance of fluconazole by 75.67% (Baktir et al., 2012). In vivo studies have shown that the ligand-enzyme combination reduced the extracellular matrix by 53.58% in a monoclonal biofilm model (Masfufatun et al., 2022). Thus, the A. fulica enzyme consortium has good potential as an antibiofilm agent. However, A. fulica is an animal that exists in certain seasons and is found in countries with tropical climates, so it takes a certain amount of time to obtain enzymes from A. fulica and can only be produced in limited quantities. To overcome this limitation, the gene encoding β-1,3-glucanase (MKAFGluI) from the digestive gland of A. fulica was cloned through library construction metagenomics. The MKAFGlu1 gene encodes a protein in the form of the enzyme 1,3-β-glucanase, which was successfully expressed in E. coli (Kurniawati et al., 2018, 2019, 2020). Expressed in the eukaryotic organism P. pastoris KM71H. In this study, 1,3-β-glucanase expressed in recombinant P. pastoris strain KM71H was used. The aim of this study was to elucidate the mechanism of recombinant β-1,3-glucanase as an antibiofilm to prevent antimicrobial resistance in antifungal therapy. Biofilm formation by C. albicans is a complex process consisting of several stages: initial adhesion, microcolony formation, maturation, and dispersion. The β-1,3-glucanase plays an important role in this process, especially by degrading the main component of the biofilm matrix, namely β-1,3-glucan. The results of this study indicate that after the 90-minute adhesion phase, there is an inhibitory effect on the initial adhesion of Candida cells treated with recombinant β-1,3-glucanase, reflecting a complex interaction between this enzyme and the structural components of the Candida cell wall. β-1,3-glucan is a major component of the fungal cell wall, including Candida, which plays an important role in maintaining structural integrity and cell adhesion (Rodríguez-Cerdeira et al., 2019; Tan et al., 2022). Previous studies have also shown that β-1,3-glucan contributes to resistance to antifungal agents by forming a biofilm matrix that protects fungal cells from drug attack (Tan et al., 2018, 2022). Furthermore, a study by de Assis et al. (2022) highlighted that modifications in β-1,3-glucan exposure can affect cell-immune cell interactions, suggesting that treatment with β-1,3-glucanase not only alters cell adhesion properties but can also modulate immune responses (de Assis et al., 2022). This suggests that therapeutic strategies targeting cell wall components such as β-1,3-glucans could have broad implications for the treatment of fungal infections. By treating Candida cells with β-1,3-glucanase, this enzyme can break down β-1,3-glucans, thereby reducing the cells’ ability to adhere and form biofilms. After the adhesion stage, C. albicans begins to colonize and form a more complex biofilm structure. The results of the study (Fig. 2) showed that the presence of recombinant β-1,3-glucanase was able to inhibit biofilm formation and degrade mature biofilm. This is further supported by the results of observations of C. albicans biofilm using SEM (Fig. 3). At this stage, β-1,3-glucanase hydrolyzes glucans, which are the main components of the biofilm matrix. β-1,3-glucans play a role in maintaining the biofilm structure and providing protection to fungal cells from attacks by antifungal agents (Tan et al., 2022). By reducing the concentration of β-1,3-glucan, β-1,3-glucanase disrupts biofilm stability, facilitating the disintegration of established biofilm structures, and thereby increasing the susceptibility of Candida cells to antifungal treatment (El-Azizi et al., 2015; Tan et al., 2018). This is important because mature biofilms are highly resistant to conventional antifungal therapy; thus, reducing the biofilm matrix can increase the effectiveness of treatment (Elisabeth et al., 2016). This study is in line with the study of Tan et al. (2018), which showed that β-1,3-glucanase can interfere with biofilm formation and increase sensitivity to antifungals (Tan et al., 2018). In addition, Wadhwa et al. (2023) also indicated that β-glucanase plays a role in changing the composition of the biofilm matrix, which contributes to increasing the effectiveness of antifungal agents (Wadhwa et al., 2023). The concentration of β-1,3-glucanase used in our study (0.216 mg/ml) showed significant effectiveness in inhibiting biofilm matrix formation as well as degrading mature biofilms. A study by Shalayel et al. (2021) confirmed that exposure to this enzyme can alter the biofilm structure and reduce the ability of fungi to adapt to adverse environmental conditions (Shalayel et al., 2021). This suggests that β-1,3-glucanase not only functions as an inhibitory agent but may also play a role in disrupting established biofilms, thereby increasing the likelihood of successful antifungal therapy. In this study, we also evaluated the synergistic effect of recombinant β-1,3-glucanase with fluconazole on the C. albicans biofilm. Based on our data, as shown in Figures 4 and 6, the ability of fluconazole to kill Candida cells in biofilms was very low. It was reported that antifungal drugs can only be found in the Candida biofilm matrix and are almost not found intracellularly because of the ability of the extracellular matrix, especially glucan, to isolate antifungal drugs (Mitchell et al., 2013). Other studies have shown that glucan molecules limit the penetration of antimicrobials into the cytoplasm of cells, including Candida species and bacteria (Nett et al., 2007; Zarnowski et al., 2014). The findings of this study suggest that recombinant β-1,3-glucanase and fluconazole work in concert: recombinant β-1,3-glucanase can break down the biofilm matrix, making Candida cells less protected by the matrix and more vulnerable to fluconazole, which increases drug efficiency. This is consistent with other studies showing that the use of enzymes like DNase can break down biofilms to release planktonic cells into the environment and increase drug penetration (Baelo et al., 2015; Brown et al., 2015). This interpretation was further supported by CLSM observations (Figs. 5 and 7). The combination of recombinant β-1,3-glucanase with Fluconazole gave weak green and red color intensities. This indicates that this combination is more effective in killing C. albicans cells and dismantling the biofilm structure, indicating that recombinant β-1,3-glucanase is better at disrupting the biofilm matrix and thus enhancing the killing of Candida cells by fluconazole. These results are in line with the study conducted by Tan et al. (2018), which found that β-1,3-glucanase can increase the effectiveness of fluconazole by disrupting the biofilm structure, which in turn increases the susceptibility of C. albicans to fluconazole (Tan et al., 2018). Other studies have also shown that β-1,3-glucanase can trigger biofilm dispersal, which is the process by which fungal cells leave the biofilm to form new infections, thereby reducing the number of cells in the biofilm that are exposed to fluconazole (Tan et al., 2017). This suggests that β-1,3-glucanase may serve as an adjunct agent in antifungal therapy. ConclusionBiofilm formation by C. albicans is a major clinical challenge because of its resistance to antifungal therapy, which is mediated by extracellular matrix components, especially β-1,3-glucan. Recombinant β-1,3-glucanase expressed in P. pastoris KM71H has been shown to degrade β-1,3-glucan at the adhesion stage, biofilm development, and mature biofilm. In addition, this enzyme shows a synergistic effect with fluconazole, which increases drug efficacy through degradation of the biofilm matrix, resulting in Candida cells becoming more susceptible to antifungal therapy. Thus, recombinant β-1,3-glucanase has the potential to act as a companion agent in antifungal therapy, especially to overcome biofilm resistance that is difficult to overcome with conventional drugs. AcknowledgmentThe author would like to thank the National Research and Innovation Agency (BRIN) and the Education Fund Management Institute (LPDP) for this research. They would also like to thank the Faculty of Medicine, Wijaya Kusuma University, Surabaya, the Institute of Tropical Disease (ITD) Laboratory, the Microbiology Laboratory, the Special Infection Hospital (RSKI) Unair, and the Central Laboratory of Life Sciences, Brawijaya University (LSIH-UB) for providing good facilities for this research. Conflict of interestThe authors declare no conflict of interest. FundingRIIM LPDP (Riset dan Inovasi untuk Indonesia Maju_Indonesia Endowment Funds for Education) Grant and BRIN (National Research and Innovation Agency) this research Batch 4. Grant: 157/IV/KS/11/2023 and 265/MoA/LPPM/UWKS/XI/2023. Author’s contributionsFor research articles with three authors, a short paragraph describing their individual contributions is required. The following statements should be used: “Conceptualization, MM and AB.; methodology, RP; formal analysis, AB; investigation, MM, RP.; resources, AB; data curation, RP; writing—original draft preparation, MM; writing—review and editing, AB, RP; supervision, MM.; project administration, RP. All authors have read and agreed to the publication of the final version of the manuscript. Data availabilityAll data supporting the findings of this study are available in the manuscript, and no additional data sources are required. ReferencesAchkar, J.M. and Fries, B.C. 2010. Candida infections of the genitourinary tract. Clin. Microbiol. Rev. 23(2), 253–273. Baelo, A., Levato, R., Julián, E., Crespo, A., Astola, J., Gavaldà, J., Engel, E., Mateos-Timoneda, M.A. and Torrents, E. 2015. Disassembling bacterial extracellular matrix with DNase-coated nanoparticles to enhance antibiotic delivery in biofilm infections. J. Control Release. 209, 150–158. Baktir, A., Suwito, H., Safinah, M. and Kunsah, B. 2012. Novel materials for eradication of biofilm extracell matrix of pathogenic Candida. J. Mater. Sci. Eng. B. 2(12), 650–658. Benincasa, M., Pacor, S., Wu, W., Prato, M., Bianco, A. and Gennaro, R. 2011. Antifungal activity of amphotericin B conjugated to carbon nanotubes. ACS Nano. 5(1), 199–208. Brown, H.L., Hanman, K., Reuter, M., Betts, R.P. and van Vliet, A.H.M. 2015. Campylobacter jejuni biofilms contain extracellular DNA and are sensitive to DNase I treatment. Front. Microbiol. 6(JUL), 1–11. Chamtouri, M., Merghni, A., Miranda-Cadena, K., Sakly, N., Gaddour, N., de Los Reyes-Gavilán, C.G., Mastouri, M., Eraso, E. and Quindós, G. 2024. Characterization of yeast isolated from the gut microbiota of Tunisian children with autism spectrum disorder. J. Fungi (Basel). 10(11), 730. de Assis, L.J., Bain, J.M., Liddle, C., Leaves, I., Hacker, C., da Silva, R.P., Yuecel, R., Bebes, A., Stead, D., Childers, D.S., Pradhan, A., Mackenzie, K., Lagree, K., Larcombe, D.E., Ma, Q., Avelar, G.M., Netea, M.G., Erwig, L.P., Mitchell, A.P., Brown, A.J.P., Gow, N.A.R. and Brown, A.J.P. 2022. Nature of b-1,3-Glucan-Exposing Features on Candida albicans cell wall and their modulation. mBio 13(6), e02605–e02622. De Bernardis, F., Graziani, S., Tirelli, F. and Antonopoulou, S. 2018. Candida vaginitis: virulence, host response and vaccine prospects. Med. Mycol. 56(1), S26–S31. El-Azizi, M., Farag, N. and Khardori, N. 2015. Antifungal activity of amphotericin B and voriconazole against the biofilms and biofilm-dispersed cells of Candida albicans employing a newly developed in vitro pharmacokinetic model. Ann. Clin. Microbiol. Antimicrob. 14(1), 1–9. Elisabeth, Z.M., Lopez, V.C., Soto, S.M. and Fabrice, F.B. 2016. Anti-Candida biofilm properties of Cameroonian plant extracts. J. Med. Plant Res. 10(35), 603–611. Kurniawati, M., Halimah, N., Hudha, M.N., Sudiyono, Purkan, Sumarsih, S. and Baktir, A. 2019. Constructing and screening beta-glucanase activity of metagenomic cDNA expression library of digestive gland of Achatina fulica. Int. J. Pharm. Res. 11(1), 67–73. Kurniawati, M., Purkan, Sumarsih, S. and Baktir, A. 2020. A novel 1,3-β-glucanase gene from the metagenomic expression library of Achatina fulica’s digestive gland. Iran. J. Pharm. Res. 19(3), 483–493. Kurniawati, M., Sumarsih, S. and Baktir, A. 2018. Metagenomic DNA library: exploration of novel genes encoding glycoside hydrolases. Int. J. Eng. 7(7), 472. Lohse, M.B., Gulati, M., Johnson, A.D. and Nobile, C.J. 2018. Development and regulation of single- and multi-species Candida albicans biofilms. Nat. Rev. Microbiol. 16(1), 19–31. Masfufatun, M., Purbowati, R., Arum, N.A., Yasinta, M.S., Sumarsih, S. and Baktir, A. 2022. An intestinal Candida albicans model for monomicrobial and polymicrobial biofilms and effects of hydrolases and the Bgl2 ligand. Vet. World. 15(4), 1134–1140. Masfufatun, M., Ratnasari D.T., Narottama, H., Purbowati, R., Indahsari, N.K. and Tjandra, L. 2024. Identification of Candida species in Vulvovaginalis Candidiasis patients and risk. Indonesian J. Infect. Dis. 10(2), 141–152. Masfufatun, M., Sudibya, A. and Indahsari, N.K. 2014. The potency of Candida albicans protein extract as bioresptor on immunocencor to diagnose candidiasis. J. Ilm. Kedokt. Wijaya Kusuma. 3(2), 26–29. Mitchell, K.F., Taff, H.T., Cuevas, M.A., Reinicke, E.L., Sanchez, H. and Andes, D.R. 2013. Role of matrix β-1,3 glucan in antifungal resistance of non-albicans Candida biofilms. Antimicrob. Agents Chemother. 57(4), 1918–1920. Nett, J. and Andes, D. 2006. Candida albicans biofilm development, modeling a host-pathogen interaction. Curr. Opin. Microbiol. 9(4), 340–345. Nett, J., Lincoln, L., Marchillo, K., Massey, R., Holoyda, K., Hoff, B., VanHandel, M. and Andes, D. 2007. Putative role of beta-1,3 glucans in Candida albicans biofilm resistance. Antimicrob. Agents Chemother. 51(2), 510–520. Nieto, J., Alvar, J., Rodríguez, C., San Andrés, M.I., San Andrés, M.D. and González, F. 2018. Comparison of conventional and lipid emulsion formulations of amphotericin B: pharmacokinetics and toxicokinetics in dogs. Res. Vet. Sci. 117, 125–132 Pierce, C.G., Vila, T., Romo, J.A., Montelongo-Jauregui, D., Wall, G., Ramasubramanian, A. and Lopez-Ribot, J.L. 2017. The Candida albicans biofilm matrix: composition, structure and function. J. Fungi (Basel). 3(1), 14. Pirotta, M.V. and Garland, S.M. 2006. Genital Candida species detected in samples from women in Melbourne, Australia, before and after treatment with antibiotics. J. Clin. Microbiol. 44(9), 3213–3217. Rodríguez-Cerdeira, C., Gregorio, M.C., Molares-Vila, A., López-Barcenas, A., Fabbrocini, G., Bardhi, B., Sinani, A., Sánchez-Blanco, E., Arenas-Guzmán, R. and Hernandez-Castro, R. 2019. Biofilms and vulvovaginal candidiasis. Colloids Surf B Biointerfaces. 174, 110–125. Sardi, J.C.O., Scorzoni, L., Bernardi, T., Fusco-Almeida, A.M. and Mendes Giannini, M.J.S. 2013. Candida species: current epidemiology, pathogenicity, biofilm formation, natural antifungal products and new therapeutic options. J. Med. Microbiol. 62(1), 10–24. Shalayel, M.H.F., Al-Mazaideh, G.M., Swailmi, F.K.A.l., Aladaileh, S., Nour, S., Afaneh, A.T. and Marashdeh, A. 2021. Molecular docking evaluation of Syzygium aromaticum isolated compounds against Exo-β-(1,3)-glucanases of Candida albicans. J. Pharm. Res. Int. 32(46), 34–44. Steimbach, L.M., Tonin, F.S., Virtuoso, S., Borba, H.L.L., Sanches, A.C., Wiens, A., Fernandez-Llimós, F. and Pontarolo, R. 2017. Efficacy and safety of amphotericin B lipid-based formulations—a systematic review and meta-analysis. Mycoses 60(3), 146–154. Tan, Y., Leonhard, M., Ma, S., Moser, D. and Schneider-Stickler, B. 2017. Dispersal of single and mixed non-albicans Candida species biofilms by β-1,3-glucanase in vitro. Microb. Pathog. 113, 342–347. Tan, Y., Ma, S., Ding, T., Ludwig, R., Lee, J. and Xu, J. 2022. Enhancing the antibiofilm activity of β-1,3-glucanase-functionalized nanoparticles loaded with amphotericin B against Candida albicans Biofilm. Front. Microbiol. 13, 815091. Tan, Y., Ma, S., Leonhard, M., Moser, D. and Stickler, B.S. 2018. β-1, 3-glucanase disrupts biofilm formation and increases antifungal susceptibility of Candida albicans DAY185. Int. J. Biol. Macromol. 108, 942–946 Tsui, C., Kong, E.F. and Jabra-Rizk, M.A. 2016. Pathogenesis of Candida albicans biofilms. Pathog. Dis. 74(4), ftw018 Vikelouda, A., Simitsopoulou, M., Kechagioglou, P., Papi, R., Kyriakidis, D. and Roilides, E. 2017. Antifungal activity of functionalized carbon nanotubes conjugated to Amphotericin-B against Candida albicans and Candida parapsilosis biofilms. Mycoses 60, 53–238. Wadhwa, K., Kaur, H., Kapoor, N. and Brogi, S. 2023. Identification of Sesamin from Sesamum indicum as a potent antifungal agent using an integrated in silico and biological screening platform. Molecules 28(12), 4658 Wall, G., Montelongo-Jauregui, D., Vidal Bonifacio, B., Lopez-Ribot, J.L. and Uppuluri, P. 2019. Candida albicans biofilm growth and dispersal: contributions to pathogenesis. Cur. Opin. Microbiol. 52, 1–6. Waykar, R. and Kumarapillai, S. 2024. Antifungal drug resistance in Candida albicans: identifying novel targets for the development of effective antifungal agents. Int. J. Pharm. Qual. Assur. 15(03), 1303–1311. Weiler, S., Bellmann-Weiler, R., Dunzendorfer, S., Joannidis, M. and Bellmann, R. 2008. Levels of amphotericin B lipid formulations in ascites. J. Antimicrob. Chemother. 62(5), 1163–1164. Weiler, S., Falkensammer, G., Hammerer-Lercher, A., Anliker, M., Vogelsinger, H., Joannidis, M., Dunzendorfer, S., Stein, M. and Bellmann, R. 2009. Pulmonary epithelial lining fluid concentrations after use of systemic amphotericin B lipid formulations. Antimicrob. Agents Chemother. 53(11), 4934–4937. Yan, Y., Tan, F., Miao, H., Wang, H. and Cao, Y.Y. 2019. Effect of shikonin against Candida albicans biofilms. Front. Microbiol. 10, 1085. Zarnowski, R., Westler, W.M., Lacmbouh, G.A., de, Marita J.M., Bothe J.R., Bernhardt, J., Lounes-Hadj Sahraoui, A., Fontaine, J., Sanchez, H., Hatfield, R.D., Ntambi, J.M., Nett, J.E., Mitchell, A.P. and Andes, D.R. 2014. Novel entries in a fungal biofilm matrix encyclopedia. mBio 5(4), 01333–01314. | ||
| How to Cite this Article |
| Pubmed Style Masfufatun M, Baktir A, Purbowati R. Mechanism of recombinant 1,3-β-glucanase as antibiofilm to prevent antimicrobial resistance in antifungal therapy for vulvovaginitis candidiasis. Open Vet. J.. 2025; 15(5): 2182-2192. doi:10.5455/OVJ.2025.v15.i5.36 Web Style Masfufatun M, Baktir A, Purbowati R. Mechanism of recombinant 1,3-β-glucanase as antibiofilm to prevent antimicrobial resistance in antifungal therapy for vulvovaginitis candidiasis. https://www.openveterinaryjournal.com/?mno=244195 [Access: January 25, 2026]. doi:10.5455/OVJ.2025.v15.i5.36 AMA (American Medical Association) Style Masfufatun M, Baktir A, Purbowati R. Mechanism of recombinant 1,3-β-glucanase as antibiofilm to prevent antimicrobial resistance in antifungal therapy for vulvovaginitis candidiasis. Open Vet. J.. 2025; 15(5): 2182-2192. doi:10.5455/OVJ.2025.v15.i5.36 Vancouver/ICMJE Style Masfufatun M, Baktir A, Purbowati R. Mechanism of recombinant 1,3-β-glucanase as antibiofilm to prevent antimicrobial resistance in antifungal therapy for vulvovaginitis candidiasis. Open Vet. J.. (2025), [cited January 25, 2026]; 15(5): 2182-2192. doi:10.5455/OVJ.2025.v15.i5.36 Harvard Style Masfufatun, M., Baktir, . A. & Purbowati, . R. (2025) Mechanism of recombinant 1,3-β-glucanase as antibiofilm to prevent antimicrobial resistance in antifungal therapy for vulvovaginitis candidiasis. Open Vet. J., 15 (5), 2182-2192. doi:10.5455/OVJ.2025.v15.i5.36 Turabian Style Masfufatun, Masfufatun, Afaf Baktir, and Rini Purbowati. 2025. Mechanism of recombinant 1,3-β-glucanase as antibiofilm to prevent antimicrobial resistance in antifungal therapy for vulvovaginitis candidiasis. Open Veterinary Journal, 15 (5), 2182-2192. doi:10.5455/OVJ.2025.v15.i5.36 Chicago Style Masfufatun, Masfufatun, Afaf Baktir, and Rini Purbowati. "Mechanism of recombinant 1,3-β-glucanase as antibiofilm to prevent antimicrobial resistance in antifungal therapy for vulvovaginitis candidiasis." Open Veterinary Journal 15 (2025), 2182-2192. doi:10.5455/OVJ.2025.v15.i5.36 MLA (The Modern Language Association) Style Masfufatun, Masfufatun, Afaf Baktir, and Rini Purbowati. "Mechanism of recombinant 1,3-β-glucanase as antibiofilm to prevent antimicrobial resistance in antifungal therapy for vulvovaginitis candidiasis." Open Veterinary Journal 15.5 (2025), 2182-2192. Print. doi:10.5455/OVJ.2025.v15.i5.36 APA (American Psychological Association) Style Masfufatun, M., Baktir, . A. & Purbowati, . R. (2025) Mechanism of recombinant 1,3-β-glucanase as antibiofilm to prevent antimicrobial resistance in antifungal therapy for vulvovaginitis candidiasis. Open Veterinary Journal, 15 (5), 2182-2192. doi:10.5455/OVJ.2025.v15.i5.36 |